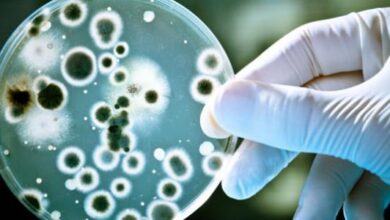

محتويات

يُعدُّ النحل من الحشرات النافعة التي تنتج العديد من المواد المفيدة بما في ذلك العسل والشّمع، ويعد الشّمع مادة طبيعيّة تنتجه فصيلة النحليات (بالإنجليزيّة: Apidae) التي ينتمي إليها نحل العسل (الاسم العلمي: Apis mellifera)، يتم أفرازها من أربعة أزواج من غدد خاصة توجد أسفل بطن العاملات (بالإنجليزيّّة: worker bees) تُعرف كلّ منها باسم الغدة الشّمعية، وتتمكن النحلة العاملة من إنتاج الشمع عند نضج الغدد الشمعية وهو ما يحدث عندما تبلغ اليوم 12-18 من عمرها، ويكون الشمع سائلاً عند خروجه من الغدد الشمعية إلا أنّه يتصلب على شكل قشور رقيقة عند ملامسته للهواء، وتحتاج النحلة إلى الكربوهيدرات الخام لإنتاج الشمع فتستهلك سكر الفركتوز، وسكر الجلوكوز، وسكر السكروز الموجود في العسل.[١][٢]
يحتاج النحل الشمع لبناء المشط الذي يشكّل الهيكل الرئيسي لمستعمرة النحل، ويُعدُّ مشط الشمع المكوّن من خلايا سداسيّة المكان الذي يعيش فيه النحل ويمارس فيه جميع مهامه اليوميّة، بالإضافة إلى أنّه مكان حفظ العسل وحبوب اللقاح التي تُعتبر المخزون الغذائي للخلية، ومكان تربية الصغار أو ما يُعرف بالحضنة،[٣] ولبناء المشط تستخدم النحلة العاملة الشّعيرات التي توجد على أرجلها الخلفية لكشط الشمع بعد أن يتماسك، وتمرره إلى الأرجل الوسطى ومنه إلى الفك حيث تقوم النحلة بمضع الشمع لتليينه، وتستخدمه بعد ذلك لبناء الخلايا سداسية الشكل التي يتكون منها مشط الشمع،[٢] ومن الجدير بالذّكر أنّ النّحل لا يبني أمشاط الشمع إلا بوجود ملكة للمستعمرة، وأنّ عدد الأمشاط التي يبنيها النحل يعتمد على مدى حاجة الخلية لمساحة تخزين، فيزداد العدد مع زيادة كمية البيض الذي تضعه الملكة، وزيادة كمية الرّحيق الذي تجمعه العاملات.[١]
فيما يأتي أهم خصائص شمع النحل:
- اللون: يكون لون الشّمع الجديد عادةً أبيض اللون، ويكون أصفر مائلاً للبرتقالي المحمر أحياناً،[٤] إلا أنّ لون الشّمع يصبح داكناً عند ملامسته لحبوب اللقاح أو العكبر الذي يستخدمه النحل لإغلاق شقوق الخلية.[٥]
- الذوبان: لا يذوب الشمع في الماء، ولكنه يذوب في المذيبات العضوية مثل البنزين، أو الإيثر، أو الكلوروفورم، ويذوب في الزّيوت والدّهون عند تعريضه للحرارة.[٤]
- درجة الانصهار: يتكون الشمع من فتات غير قابلة للذوبان ولكنه ينصهر عند تعرضه لدرجة حرارة عالية تتراوح بين 62-65 درجة مئوية.[٤]
- القوام: يكون الشمع البارد على شكل كتلة هشة سهلة التّفتت، إلا أنّه ينكمش ويصبح أكثر كثافة عند تعرضه للحرارة المنخفضة.[٤]
تبذل العاملات الكثير من الجهد لإنتاج ما تحتاجه من الشمع لبناء المشط، ويمكن تخيل مدى الجهد المبذول إذا علمنا أنّ النحلة العاملة تستغرق 12 ساعة لإنتاح 8 قشور من الشمع، في حين تحتاج إلى 1000 قشرة شمع لإنتاج غرام واحد من الشمع،[٢] لذلك اهتدى النحل لبناء المشط على شكل خلايا سداسية الأضلاع، ويتميّز التصميم السّداسي بأنّه يستهلك أقل كمية ممكنة من الشمع لبناء خلايا ذات مساحة تخزينية واسعة تتميّز بالقوة والمتانة، ودون ترك فراغات بينها في آنٍ واحد، بالإضافة إلى أنّ بناء الخلايا السداسية لا يحتاج إلى الكثير من الوقت والجهد؛ مما يعني أنّ النحل يمكنه استغلال وقته وجهده للقيام بالمهام الضّرورية الأخرى.[٦]
عرف الإنسان شمع النحل منذ قديم الزّمان واستخدمه لتحنيط الموتى، وصناعة الشّموع، والدمى، والأقنعة، بالإضافة إلى العديد من الاستخدامات الحديثة المتنوعة نذكر منها:[٧]
- يُستخدم الشمس في صناعة مستحضرات التجميل بما في ذلك واقيات الشّمس، ومزيلات العرق، ومزيلات الشّعر، وكريمات الشعر، وأحمر الشفاه، وظلال العيون، وذلك لقدرته على تحسين مظهر وتجانس الكريمات والمستحضرات، واحتوائه على خصائص المضادات الحيوية، بالإضافة إلى أنّه لا يثير ردود فعل تحسسيّة.[٧]
- يُستخدم في تركيب ملونات الطّعام، والمواد الحافظة للأغذية، وكغلاف للحلوى المصنوعة من الشكولاتة، والمخبوزات والفاكهة، والمكسرات نظراً لكونه مادة خاملة لا تتفاعل مع الجهاز الهضمي للإنسان وتمر عبر الجسم دون أن تتغير مالم يتم تخزينها بالقرب من المواد الكيميائية السّامة والمبيدات الحشرية.[٧]
- يُستخدم لتغليف الأدوية التي تكون على شكل حبوب لتسهيل بلعها ولتأخير الإفراج عن المادة الدّوائية في الجسم.[٧]
- يُستخدم الشمع الدافئ لزيادة مرونة الجلد، ولعلاج التهاب العضلات والأعصاب، والمفاصل.[٧]
- يفيد عند مضغه في تقوية اللثة وزيادة كمية اللعاب.
- يُستخدم في طلاء السّيارات، وتلميع الأثاث والأرضيات والجلود والأحذية.[٥]
- يُستخدم لطلاء المسامير لزيادة قدرتها على اختراق الخشب دون بذل الكثير من الجهد.[٥]
- يُستخدم لصنع القوالب بما في ذلك القوالب التي يستخدمها طبيب الأسنان.[٥]
- يستخدم لتشميع خيوط وإبر الخياطة لتسهيل وتسريع الخياطة.[٥]
للتعرف أكثر على مملكة النحل يمكنك قراءة المقال مملكة النحل
- ^ أ ب Stefan Bogdanov , Beeswax, Page 1,2. Edited.
- ^ أ ب ت Debbie Hadley (6-2-2019), “How Honey Bees Make Beeswax”، www.thoughtco.com, Retrieved 22-6-2020. Edited.
- ↑ Christy Hemenway, The Thinking Beekeeper: A Guide to Natural Beekeeping in Top Bar Hives, Canada: New Society Publishers, Page 11-12. Edited.
- ^ أ ب ت ث Marieke Mutsaers, Henk Blitterswijk, Leen Leven, and others (2005), Bee products, Wageningen: Agromisa Foundation, Page 44.
- ^ أ ب ت ث ج “BEESWAX”, agdev.anr.udel.edu/maare, Retrieved 22-6-2020. page 1,5 Edited.
- ↑ “Why do bees make hexagons in their hives”, askdruniverse.wsu.edu, Retrieved 21-6-2020. Edited.
- ^ أ ب ت ث ج Stefan Bogdanov , The Beeswax Book, Page 1،10،11،12. Edited.